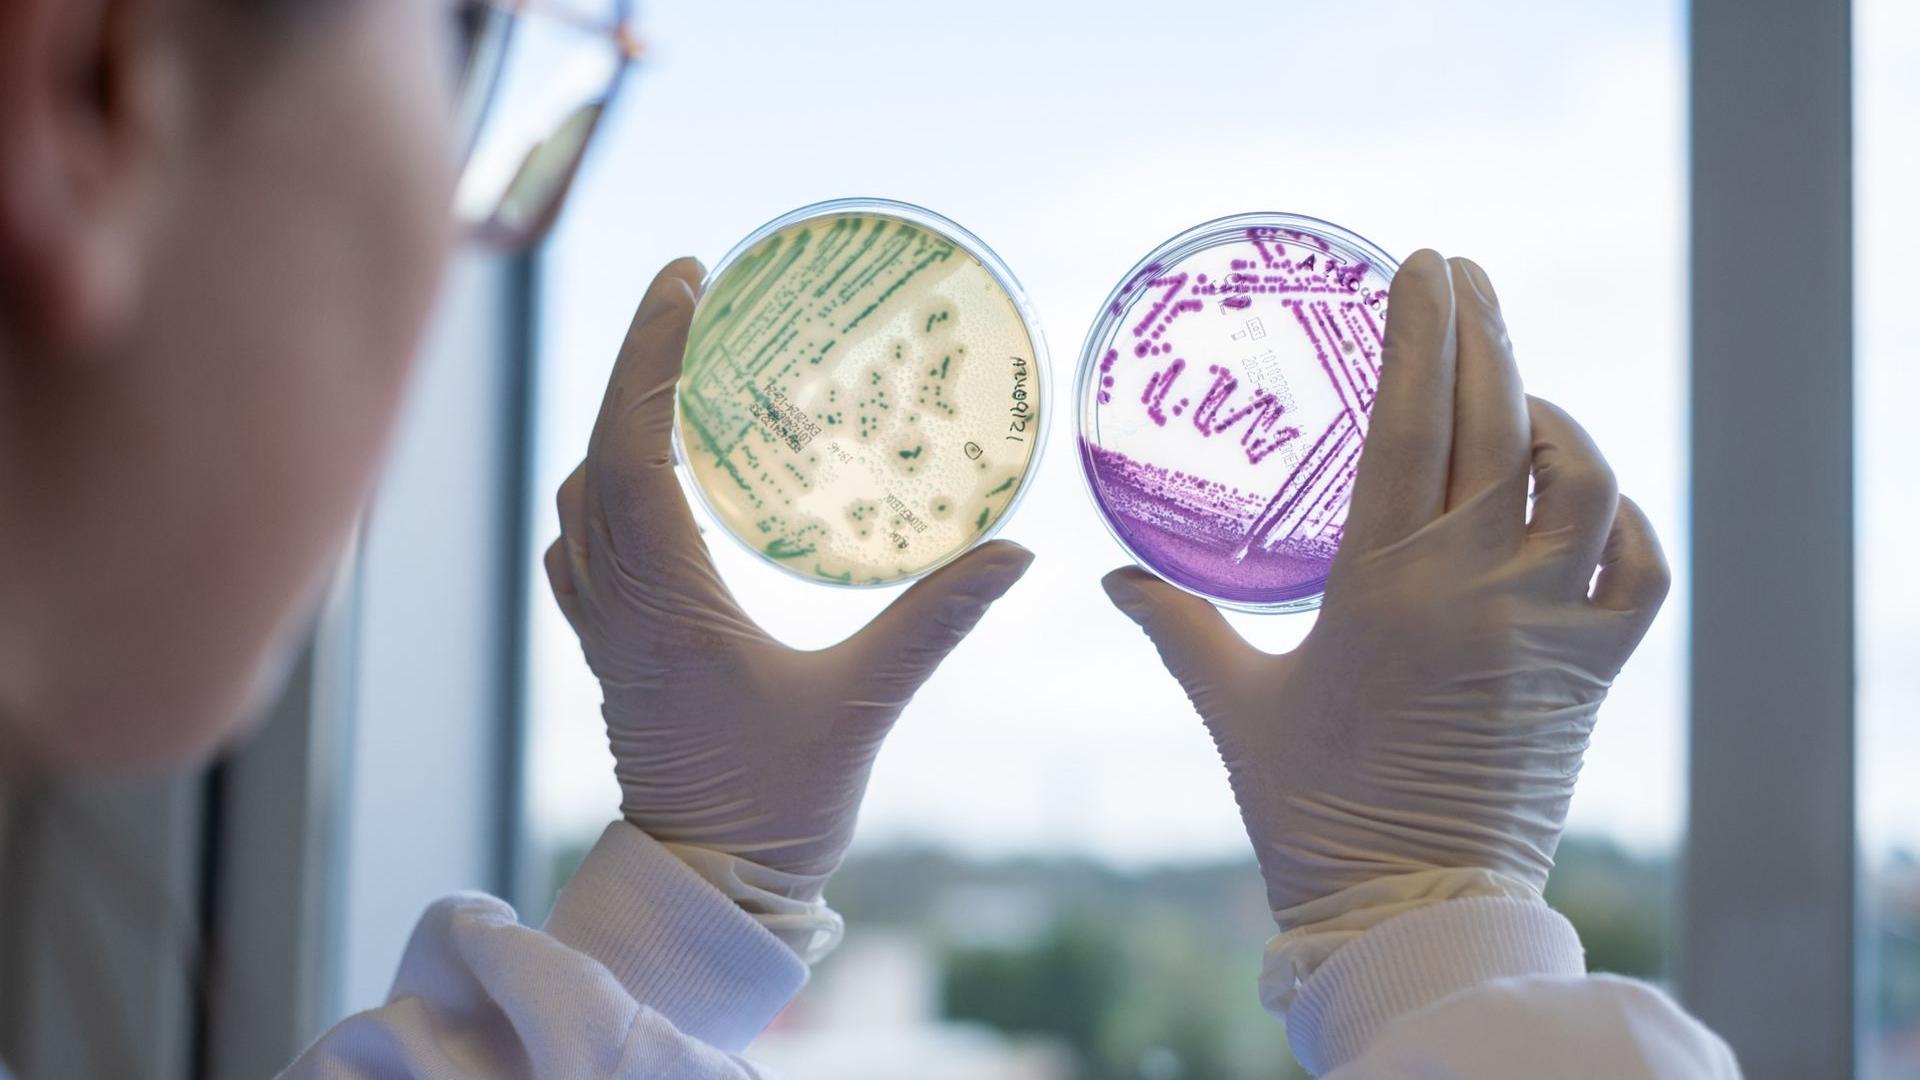

Líneas estratégicas I+D+i
Nuestras líneas de trabajo se centran en el desarrollo de proyectos y la prestación de servicios innovadores diseñados específicamente para atender las necesidades de las empresas agroalimentarias
Participamos activamente en la innovación, colaborando como socios en consorcios europeos, nacionales y regionales.
En los últimos años, hemos crecido de manera notable en este ámbito, lo que nos ha valido el reconocimiento como Agrupación Empresarial Innovadora de Excelencia y Centro Tecnológico (Reg. 127).
Nuestra actividad en innovación tecnológica se enfoca en ofrecer servicios y desarrollar proyectos estratégicos, siempre alineados con las necesidades de las empresas del sector agroalimentario.

Desarrollo de nuevos productos
- Alimentos saludables y funcionales
- Mejora del perfil nutricional de los productos elaborados
- Optimización de procesos térmicos
- Alimentación en envejecimiento activo
- Alimentación para deportistas
- Obtención de ingredientes de alto valor añadido (funcionales y saludables) a partir de coproductos de la industria alimentaria
- Desarrollo de nuevos alimentos adaptados a nuevos hábitos de consumo a partir de excedentes y destríos

Nuevas estrategias y tecnologías de conservación
- Optimización de parámetros en procesos térmicos tradicionales
- Implementación de nuevas tecnologías no-térmicas (altas presiones, biopasteurización, etc)
- Implementación de métodos de conservación combinados
- Implementación de objetivos de seguridad alimentaria en procesos productivos
- Optimización del uso de sistemas de envasado
- Nuevos materiales de envasado
- Envases activos e inteligentes
- Validación de plásticos biodregradables para alimentos

Nuevos procesos de fabricación
- Sistemas de calidad online
- Desarrollo de tecnologías rápidas online (Tecnología NIR) para el desarrollo de modelos predictivos de vida últil
- Desarrollo de tecnologías rápidas online para la clasificación y evaluación de materias primas y productos terminado
- Desarrollo de tecnologías rápidas online para la evaluación de higiene de superficies de trabajo
- Sensorización inteligente de plantas de fabricación para el control de parámetros
- Recopilación y análisis de datos para la toma de decisiones en planta
- Control automatizado de mermas en procesos productivos para el control de costes
- Mejora de la eficiencia energética mediante la automatización y análisis de consumos
Biotecnología aplicada a la seguridad alimentaria
- Control de poblaciones bacterianas
- Desarrollo de Challenge test
- Identificación y evaluación de la capacidad tecnológica de cepas microbiológicas específicas
- Aislamiento, caracterización y trazabilidad de cepas salvajes
- Sistemas de biopasteurización
- Incremento y control de la vida útil
- Optimización de procesos productivos y fermentativos
- Desarrollo de biosensores
- Estudio de la capacidad conservante de compuestos antimicrobioanos
- Desarrollo y validación de métodos analíticos en microbiología de alimentos

Bioeconomía
- Valorización de co-productos de la industria alimentaria para la obtención de ingredientes de alto valor añadido
- Aprovechamiento de subproductos vegetales para la obtención de alimentos adaptados a nuevos hábitos de consumo
- Valorización de subproducto para su aplicación en producción primaria (piensos, abonos, etc)